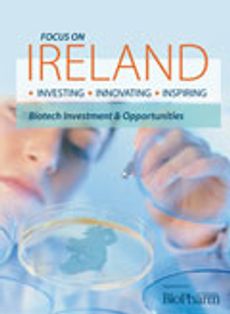
BioPharm International-12-15-2005

BioPharm International

BioPharm International-05-01-2006
Volume: 19
Issue: 5

BioPharm International-04-01-2006
Volume: 19
Issue: 4

BioPharm International-03-01-2006
Volume: 19
Issue: 3

BioPharm International-03-10-2006
Volume: 2006 Supplement
Issue: 2

BioPharm International-02-01-2006
Volume: 19
Issue: 2

BioPharm International-02-09-2006
Volume: 2006 Supplement
Issue: 1

BioPharm International-01-01-2006
Volume: 19
Issue: 1
BioPharm International-12-15-2005
Volume: 2005 Supplement
Issue: 4

BioPharm International-12-01-2005
Volume: 18
Issue: 12

BioPharm International-11-01-2005
Volume: 18
Issue: 11

BioPharm International-10-01-2005
Volume: 18
Issue: 10

BioPharm International-09-01-2005
Volume: 18
Issue: 9

BioPharm International-09-15-2005
Volume: 2005 Supplement
Issue: 3

BioPharm International-08-01-2005
Volume: 18
Issue: 8

BioPharm International-08-10-2005
Volume: 2005 Supplement
Issue: 2

BioPharm International-07-01-2005
Volume: 18
Issue: 7

BioPharm International-06-01-2005
Volume: 18
Issue: 6

BioPharm International-05-01-2005
Volume: 18
Issue: 5

BioPharm International-04-01-2005
Volume: 18
Issue: 4

BioPharm International-03-01-2005
Volume: 18
Issue: 3
BioPharm International-03-10-2005
Volume: 2005 Supplement
Issue: 1

BioPharm International-02-01-2005
Volume: 18
Issue: 2

BioPharm International-01-01-2005
Volume: 18
Issue: 1

BioPharm International-12-01-2004
Volume: 17
Issue: 12

BioPharm International-11-15-2004
Volume: 2004 Supplement
Issue: 5

BioPharm International-11-01-2004
Volume: 17
Issue: 11

BioPharm International-10-15-2004
Volume: 2004 Supplement
Issue: 4

BioPharm International-10-01-2004
Volume: 17
Issue: 10

BioPharm International-09-01-2004
Volume: 17
Issue: 9

BioPharm International-09-15-2004
Volume: 2004 Supplement
Issue: 3
Advertisement
Advertisement
Trending on BioPharm International
1
China Approves First Monthly Biologic for COPD
2
FUJIFILM Irvine Scientific Rebrands as FUJIFILM Biosciences
3
Ultragenyx Phase III Data Reveal Limits of Bone Density Endpoints in Rare Bone Disease
4
CDC Revises Childhood Immunization Schedule, Shifting Demand Dynamics
5
